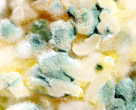

Ratgeber zur Luftreinigung / Luftreiniger
Belastete Raumluft
Die Qualität unserer Atemluft hat sich in den letzten 20 Jahren
deutlich verschlechtert. Über eine Vielzahl von Studien kommen führende
Umweltschutzverbände zur Erkenntnis, dass die Schadstoffbelastung in
Innenräumen teilweise bis zum 100-fachen Wert höher liegt als
die Luftverschmutzung im Freien. Die Folgen können an den permanent
zunehmenden Beschwerden bei Atemwegsproblemen und steigenden Allergieraten
nur allzu gut nachvollzogen werden. Alle 10 Jahre steigt die Zahl der Asthmaerkrankungen
um 50% an. Dadurch wird nicht nur die Gesundheit der Betroffenen, sondern
auch deren Leistungsfähigkeit stark eingeschränkt. Millionen von
Fehltagen am Arbeitsplatz und in der Schule sowie therapeutische Behandlungen
verursachen im Gesundheitswesen Kosten in Milliardenhöhe. Geeignete
HEPA Luftreiniger filtern gefährliche Partikel aus der Raumluft und
können den gesundheitlichen Beschwerden entgegenwirken.
Problematik:
 |

|
 |
|
| Tabak- & Zigarettenrauch |
Allergener Hausstaub |
Schadstoffe Chemiekalien |
Schimmelpilze Keime & Bakterien |
Gefilterte, saubere Atemluft
Schlechte Luft Zuhause oder im Büro macht auf Dauer krank. Sobald erste
Anzeichen für eine Anfälligkeit auftreten ist ein Hepa Luftreiniger
eine Investition in die eigene Gesundheit. Die Luftfilter schaffen bessere
Atemluft, dadurch verringert sich die Anfälligkeit für Krankheiten.
Tabakrauch, schlechter Geruch, Schimmelsporen aber auch allergene Hausstaubpartikel
werden abgefiltert und größtenteils eliminiert.
Hepa Luftreiniger: Wirksames Filtersystem für reine Luft
Filterspektrum
Hepafilter sind ein Ergebnis der Weltraumforschung. Heute werden sie erfolgreich
in Klinik, Labor, Büro und im Privathaushalt eingesetzt. Bis zu 99,99%
der Staubpartikel bis zu einer Größe von 0,3 Mikrometer werden
durch gute Luftreiniger abgefiltert und gebunden. Die Filtration und Luftreinigung
entfernt die nachstehenden Partikel:
| Hausstaub, Feinstaub | Blütenstaub, Pollen | |||
| Tabak- & Zigarettenrauch | Flüchtige Stoffe, VOC | |||
| Schimmel, Sporen, Keime | Gerüche , Gase | |||
| Tierhaare von Katze & Hund | Bakterien, Viren |
HEPA Luftreiniger für mehr Wohlbefinden
Luftverschmutzung in Innenräumen ist eine der Hauptursachen für
Krankheiten wie Asthma, Allergie, Neurodermitis, chronische Kopfschmerzen,
Müdigkeit und Unwohlsein. Dies nicht zuletzt auch deshalb, weil wir
uns heutzutage im Durchschnitt zwischen 15 und 22 Stunden täglich
in geschlossenen Räumen aufhalten. Wissenschaftler haben über
1500 bakteriologische und chemische Luftverschmutzer identifiziert. So
gehören Staubmilben und der feine Milbenkot mit zu den stärksten
biologischen Allergenen. In Deutschland sind über 5 Millionen Menschen
von der Hausstauballergie betroffen. Wohngifte, wie Holzschutzmittel,
Lindan, PCP, Pyrethroide, chemische Lösungsmittel, Benzol, Xylol,
Toluol, Formaldehyd, Asbest stellen eine weitere große (meist unentdeckte)
Gefahr für unsere Gesundheit dar. Auch Bakterien und Schimmelpilze
benutzen den in der Luft schwebenden Staub als Fortbewegungsmittel auf
dem Weg in unsere Lunge. Hepa Luftreiniger reduzieren diese Partikel in
unserem Zuhause, im Büro oder in öffentlichen Räumen.




